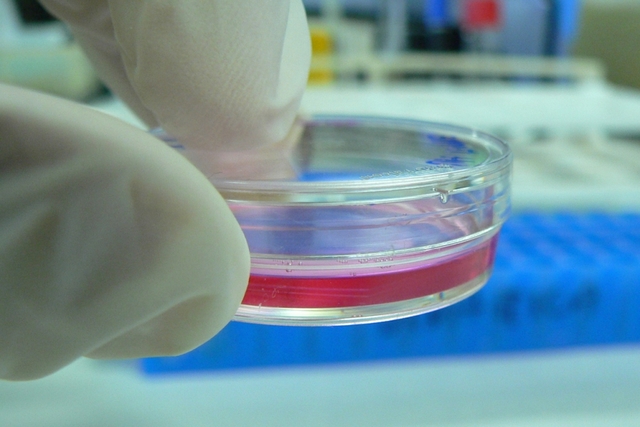
Cultivo semisintético

-
Girolano Fracastoro había sugerido que las enfermedades podían deberse a organismos tan pequeños que no podían verse y que eran transmitidos de una persona a otra.
-
Zacharias Janssen fue el inventor del microscopio compuesto de dos lentes.
Los primeros microscopios compuestos producidos por los Janssen eran simplemente un tubo de 45 cm de largo y 5 cm de diámetro con una lente convexa en cada extremo. Este instrumento llegó a tener entre 3 y 9 aumentos, dependiendo del tamaño de la abertura del diafragma. -
En 1665 Robert Hooke publicó el libro "Micrographía", el relato de 50 observaciones microscópicas y telescópicas con detallados dibujos. Este libro contiene por primera vez la palabra "célula" y en él se apunta una explicación plausible acerca de los fósiles.
Hooke descubrió las células observando en el microscopio una lámina de corcho, dándose cuenta de que estaba formada por pequeñas cavidades poliédricas que recordaban a las celdillas de un panal. Por ello cada cavidad se llamó célula. -
Francesco Redi publicó un libro titulado "Experienze in torno de la generazione deg'Insetti" en el que planteó un experimento sencillo pero contundente para refutar las creencias acerca de la aparición súbita y espontánea de los seres vivos, aquí demostró que los gusanos encontrados en la carne podrida eran larvas que provenían de los huevos que previamente habían depositado en la carne las moscas y no el producto de la generación espontánea.
-
Estudiando al microscopio una muestra de agua de un charco, Antony van Leeuwenhoek encontró organismos vivos a los que llamó "animálculos": así se abría ante sus ojos y los de los demás observadores un mundo microscópico.
-
Robert Hooke demostró ante la Real Sociedad que los "animalitos" o "animáculos" que Leeuwenhoek había visto eran reales.
-
Leeuwenhoek identifica y cataloga los protozoos, bacterias, espermatozoides y glóbulos rojos en la sangre. Observó el ciclo reproductor de ciertos insectos.
-
John Needham hirvió trozos de carne para destruir los organismos preexistentes y los colocó en un recipiente abierto. Al cabo de un tiempo observó colonias de microorganismos sobre la superficie y concluyó que se generaban espontáneamente a partir de la carne.
-
Lazzaro Spallanzani repitió el experimento de Needham pero tapando los recipientes, no apareciendo las colonias, lo que contradecía la teoría de la generación espontánea. Pero Needham argumentó que el aire era esencial para la vida incluída la generación espontánea de microorganismos y este aire había sido excluido en los experimentos de Spallanzani.
-
El inglés Edward Jenner hizo la primera inoculación contra la viruela. James Phipps, un niño de ocho años de edad, fue el primer inoculado con secreción recogida de una pústula vacuna (viruela de vacas) en la mano de una lechera que se había infectado durante un ordeño. El primero de julio siguiente inoculó de nuevo al pequeño.
-
Agostino Bassi, comienza a estudiar una dolencia que atacaba al Bombyx mori o gusano de seda, conocida como "mal de sueño", actualmente llamada muscardina. La larva se cubría de un polvo blanco y moría. Los cultivos fueron prácticamente abandonados en su totalidad. .
-
Bacillus subtilis es una bacteria Gram positiva, Catalasa-positiva, aerobio1 comúnmente encontrada en el suelo. Miembro del Género Bacillus, B. Subtilis tiene la habilidad para formar una resistente endospora protectora, permitiendo al organismo tolerar condiciones ambientalmente extremas.
-
Agostino Bassi, demuestra que la muscardina era provocada por un cierto tipo de hongo que nombra Botrytis paradoxa (actual Beauveria bassiana). Describe la forma de eliminar y de prevenir aquel hongo, lo que ayuda a la industria de la seda notablemente. Bassi publica los resultados de sus estudios y describe una teoría que explica numerosas dolencias vegetales, animales y de humanos por organismos patogénicos. Refuerza así, la teoría de que las enfermedades contagiosas como la variola.
-
Miles Joseph Berkeley, descubre un hongo (Phytophthora infestans) que produce la podredumbre de la patata.
-
Ignacio Felipe Semmelweis fue un médico húngaro que consiguió disminuir drásticamente la tasa de mortalidad en un 70 % por sepsis puerperal (una forma de fiebre puerperal) entre las mujeres que daban a luz en su hospital mediante la recomendación a los obstetras de que se lavaran las manos con una solución de cal clorurada antes de atender los partos.
-
John Snow, demostró que el cólera era causado por el consumo de aguas contaminadas con materias fecales, al comprobar que los casos de esta enfermedad se agrupaban en las zonas donde el agua consumida estaba contaminada con heces. Ese año cartografió en un plano del distrito de Soho los pozos de agua, localizando como culpable el existente en Broad Street, en pleno corazón de la epidemia.
-
Sergei Winogradsky inició el concepto de ciclo de la vida.
-
Louis Pasteur utilizó el primer medio de cultivo semisintético a base de sales de amonio, restos de levadura de cerveza y azúcar.
-
Luis Pasteur descubrió que todos los procedimientos fermentativos son resultado de la actividad microbiana e introdujo los conceptos de aerobiosis y anaerobiosis.
-
Friedrich Miescher comenzó sus investigaciones con los espermas de los salmones y descubrió la presencia de una serie de sustacias una acida y una fuertemente básica a la que denomino protamina y que se identifica con las histonas.
-
Robert Koch aisló bacterias de cultivos y definió las bacterias como agentes etiológicos de enfermedades (Etiología es la parte de la medicina que estudia el origen o las causas de las enfermedades).
-
Robert Koch demuestra que el carbunco o ántrax es causado por Bacillus anthracis.
-
Lord Joseph Lister médico escocés, ideo la denominada técnica de las Diluciones para obtener cultivos puros en medios líquidos.
-
Robert Koch visualiza el agente causante del carbunco (Bacillus anthracis), a partir de preparaciones fijadas y teñidas con azul de metileno y en 1882, el agente etiológico de la tuberculosis (Mycobacterium tuberculosis). Este método seria perfeccionado por Ziehl en 1882 y Neelsen en 1883,y hoy se conoce como tinción de acido-alcohol resistente.
-
Carlos Finlayo descubrió la importancia del vector biológico de la teoría metaxenica de la transmisión de enfermedades por agentes biológicos produciendo una fiebre amarilla por el mosquito.
-
El primer medio sólido que Robert Koch empleo fue la superficie de una rodaja de patata cocida. Posteriormente introdujo el uso de la gelatina como agente solidificante.
-
Pasteur abordó la inmunización artificial por medio de vacunas
-
Theordor Escherich descubre una bacteria que vive en el intestino, estas bacterias no producen problemas en general, pero algunos tipos pueden producir molestias y diarrea.
-
Richard Petri introduce el uso de las cajas Petri para el cultivo de células.
-
Beijerinck aísla bacterias fijadoras de nitrógeno de los nódulos presentes en las raíces de leguminosas.
-
Sergei Winograndsky y Marinus Willem Beijerinck, desarrollaron independientemente las técnicas de cultivo de enriquecimiento que sirvieron para demostrar de forma determinante el papel que juegan los microorganismos como agentes geoquímicos – ciclos del Carbono, Nitrógeno y Azufre – para el reciclado de la materia orgánica.
-
Winograndsky descubrió las bacterias quimiolitótrofas y desarrolló técnicas de cultivo apropiadas para el crecimiento de estos organismos.
-
Los postulados de Koch (basados en postulados simulares descritos 50 años antes por F.G.L Henle): 1.- El microorganismo debe presentarse en todos los casos de la misma enfermedad.
2.- El microorganismo debe de poderse aislar del hospedador enfermo y obtenerse un cultivo propio.
3.- La enfermedad debe reproducirse cuando el cultivo puro del microorganismo se inocula en un hospedador sano.
4.-El microorganismo debe ser recuperable a partir del hospedador inyectado experimentalemente. -
Adolf Meyer y Dimitri Ivanowsky descubrieron los virus al estudiar el agente etiológico causante del Mosaico del tabaco. De esta forma nace la virología.
-
El primer virus identificado fue el virus del Mosaico del tabaco, fue descubierto independientemente por Dimitri Iwanowsky en Rusia y por Beijerinck en Holanda.
-
Fritz Chauddin Y Erich Hoffmann demuestran que el treoponema palidum es el productor de la sífilis, Schaudinn estudió el ciclo vital de diferentes protozoos y con la ayuda de Hoffmann descubrieron cual era el agente productor de la sífilis.
-
Wright y Douglas hacen un trabajo que concilia la hipótesis celular y la base humoral de la inmunidad, mostrando que ambas eran correctas.
-
Howard Taylor descubrió que la fiebre en montañas rocosas era transmitida por garrapatas, irónicamente el falleció por esta fiebre.
-
Paul Ehrlich descubre el salvarsán (balas mágicas), primer agente quimioterapéutico contra la sífilis.
-
Francis Peyton Rous descubre el virus (retrovirus) que produce tumores (sarcomas) en pollos.
-
Frederick Twort descubrió los virus que parasitan a las bacterias o bacteriófagos.
-
-
Desarrollo del microscopio ultravioleta por August Kohler y Moritz van Rohr.
-
Se publica por primera vez el Manual Bergey de Microbiología.
-
Alexander Fleming elaboró el primer antibiótico de la historia, la penicilina (producida por el hongo filamentoso Penicillium notatum), inaugurando así la antibiosis.
-
Frederick Griffith lleva acabo el descubrimiento de la transformación bacteriana.
-
Frits Zernike desarrolla el microscopio de contraste de fases que permite ver microorganismos vivos.
-
-
Wendell Meredith Stanley, consigue cristalizar el virus del mosaico del tabaco (que permaneció activo después de la cristalización).
-
George Wells Beadle y Edward Lawrie Tatum obtuvieron a través de la mutagénesis de rayos X los primeros mutantes auxótrofos de un hongo (Neurospora crassa). Los mutantes auxótrofos son aquellos que no son capaces de producir algún metabolito esencial para su desarrollo, es decir, son defectivos en alguna ruta metabólica sintética.
-
Oswald Avery, Colin MacLeod y Maclyn McCarty, demuestran que el DNA es el material genético.
-
-
Joshua Lederberg y Lawrie Tatum consiguieron realizar el primer intercambio de genes entre bacterias.
-
Comienza la elaboración de medios de cultivos deshidratados.
-
Alfred Hershey y Martha Chase demuestran que el DNA era el material genético de algunos virus, el material genético esta formado por moléculas de DNA el cual se emplea para guardar la información genética de una forma de vida orgánica.
-
James D. Watson y Francis Crick consiguen diluciar la estructura en doble helice del DNA mediante estudios de difracción de rayos X la estructura molecular de doble hélice del DNA.
-
Estudios de Baltimore sobre transcriptasa inversa de los retrovirus.
-
Woese y George E. Fox reconocen las archeas como el tercer dominio de los seres vivos.
-
-
Se produce insulina humana usando bacterias escherichia coli (E. Coli) mediante técnicas de ingeniería genética.
-
Detección de los priones por Prusiner.
-
Koch descubrió un bacilo al que se llamó bacilo de Koch (Mycobacterium tuberculosis), causante de la tuberculosis, recibiendo por sus hallazgos el premio Nobel de Medicina en 1905.
-
Koch descubrió el bacilo causante del cólera (Vibrio cholerae).
-
Las bacterias son microorganismos procariotas que presentan un tamaño de unos pocos micrómetros (por lo general entre 0,5 y 5 μm de longitud) y diversas formas incluyendo filamentos, esferas (cocos), barras (bacilos), sacacorchos (vibrios) y hélices (espirilos). Las bacterias son células procariotas, por lo que a diferencia de las células eucariotas (de animales, plantas, hongos, etc.), no tienen el núcleo definido ni presentan, en general, orgánulos membranosos internos.
-
Craig Venter y Hamilton Smith secuenciaron el primer genoma de un organismo procariota (Haemophilus influenzae).
-
Se secuencia el genoma de la bacteria haemophilus influenzae. La mayoría de las cepas de H. influenzae son patógenos oportunistas, estos tipos de patógenos viven en su huésped sin causar enfermedades, pero pueden causar problemas cuando otros factores crean una oportunidad infecciosa.
-
Se secuencia el genoma del hongo saccharomyces cerevisiae.
-
Se descubre la bacteria gigante thiomargarita mamibiensis, es una bacteria con forma de coco que alcanza, de media, los 0.1-0.3 mm de diámetro, pudiendo incluso a llegar a los 0.75 mm. Este tamaño está por encima del poder de resolución del ojo, por lo que es posible detectar su presencia sin necesidad de emplear microscopios.
-
Heidelberg y Col. descubren que Vibrio Cholerae tiene dos cromosomas circulares.
-
Hopwood y Col. realizaron la secuenciación del genoma de Streptomyces Coelicolor.
-
Aparece en Asia la gripe aviar, producida por el subtipo H5N1 del virus Influenza A que puede transmitirse al hombre.
-
Secuenciación del genoma de Legionella Pneumophila, el microorganismo productor de la enfermedad de los legionarios. También responsable de la mayoría de las infecciones en humanos. Es el origen del 10% de los casos de neumonía, tanto en las adquiridas en la comunidad como en las hospitalarias.
-
-En México aparece un brote de gripe porcina, posteriormente llamada gripe A H1N1.
-Se descubre el proceso de esporulación en Mycobacterium.
-Bacillus Subtilis puede producir dos esporas en la misma célula madre.
-Caracterización "in vivo" e "in vitro" del virus H1N1.
A list shows items. A timeline shows sequence.
Use Timetoast to make dates, milestones, and turning points easier to understand in a clear visual format. Timetoast is a timeline maker for work, school, research, and stories.